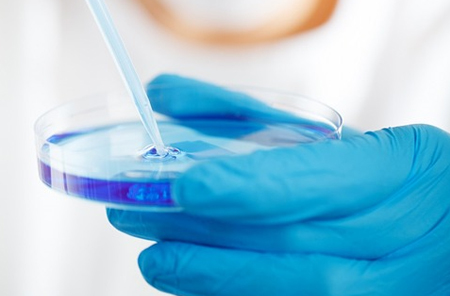

ELISA(enzyme-linked immunosorbent assay)是以物理方法將抗體或抗原吸附在固體載體上,使酶標(biāo)記的抗原抗體反應(yīng)在固相表面上進(jìn)行,最后通過顯色反應(yīng)來檢測(cè)抗原或抗體的方法。
ELISA是目前應(yīng)用廣泛的一種免疫測(cè)定方法。與其他血清學(xué)方法相比,ELISA方法具有敏感特異、操作簡(jiǎn)便、重復(fù)性高以及樣本用量少等特點(diǎn),適合于各類實(shí)驗(yàn)室開展研究分析及檢測(cè)應(yīng)用。
近年來,基因工程技術(shù)的快速發(fā)展,純度高、活性好、結(jié)構(gòu)背景清晰的重組蛋白得以廣泛應(yīng)用,加之各種自動(dòng)化酶免疫檢測(cè)儀器的迭代出現(xiàn),不僅大幅提高了該檢測(cè)技術(shù)的性能,也提高了其檢測(cè)效率,從而使得ELISA這一經(jīng)典的免疫學(xué)檢測(cè)方法又成為當(dāng)前最有活力的檢測(cè)工具之一。